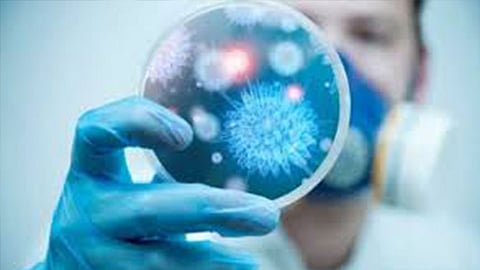

أعلنت السلطات الصحية في الصين، اليوم الأحد، تسجيل 10 حالات وفاة بين المصابين بفيروس كورونا، أمس السبت، ما يرفع إجمالي الوفيات في البلاد إلى 3 آلاف و199 حالة.
وذكرت السلطات أنه تم تسجيل 20 إصابة إضافية مؤكدة بحلول نهاية يوم أمس السبت 14 مارس، وفقًا لوكالة أنباء بلومبرج.